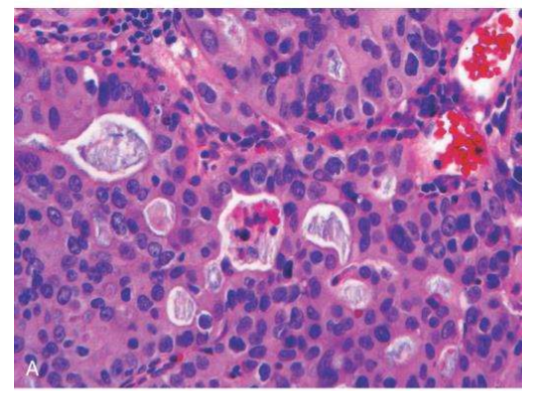

A: normal gastroesophageal junction
B: Barrett esophagus; note the small islands of paler squamous mucosa within the Barrett mucosa

describe the image

C: histologic appearance of the gastroesophageal junction in Barrett esophagus; note the transition between esophageal squamous mucosa (left) and metaplastic mucosa containing goblet cells (right)

describe the etiology of the condition seen in the image

- long-standing acid reflux esophagitis → GERD
- more common in males
- more common in whites
- GERD is caused by:
- obesity
- limited scleroderma (CREST)
- E = esophageal dysmotility → GERD
- anti-centromere positive, hiatal hernia

describe the pathogenesis of the condition seen in the image

- decreased tone in LES → genetic reprogramming of stem cells in the lower 1/3 of the esophagus
- proliferation of progenitor cells for healing which then differentiate into columnar cells → more resistant to peptic acid injury

describe the presentation of the condition seen in the image

- presentation is similar to reflux
- heart burn → worse when lying down
- dyspepsia
- waterbrush (bad metallic taste of acid in mouth)
- epigastric pain
- substernal discomfort relieved by antacids

definitive diagnosis of the condition seen in the image is accomplished by ____

definitive diagnosis of the condition seen in the image is accomplished by upper GI endoscopy and biopsy
- endoscopy: normal pearly white esophageal squamous mucosa → velvety pink columnar mucosa

describe complications of the condition seen in the image

- # 1 risk factor for dysplasia → adenocarcinoma of the esophagus
- ALWAYS d/t Barrett’s
- progressive dysphagia and odynophagia
- melena → iron deficiency anemia

describe the etiology of the condition seen in the image

- more common in US
- precursor lesion = GERD, Barrett esophagus (dysplasia)
- lower 1/3 of esophagus

_____ is the precursor lesion to the condition seen in the image

GERD → Barrett esophagus is the precursor lesion to the condition seen in the image

describe the risk factors for the condition seen in the image

- white men, smokers, obese, previous radiation therapy

describe the presentation of the condition seen in the image
- presentation:
- signs and symptoms similar to SCC
- dysphagia, initially to solid then to liquid
- odynophagia
- weight loss → cachexia
- chest pain
- vomiting

describe the complications of the condition seen in the image

- complications:
- melena → iron deficency anemia
- TEF → aspiration pneumonia → lung abscess
- invade heart → pericarditis → percardial effusion

describe the image

squamous cell carcinoma composed of nests of malignant cells that partially recapitulate the stratified organization of squamous epithelium

describe risk factors of the condition seen in the image

- etiology:
- fungal contamination
- nitrites (smoked food)
- alcohol
- tobacco use
- GERD
- achalasia
- Tylosis: oral leukoplakia, SCCE, hyperkeratosis of palms and soles
- Plummer-Vinson
- characterized by difficulty in swallowing, iron-deficiency anemia, glossitis, cheilosis and esophageal webs
- Celiac disease

describe the pathogenesis of the condition seen in the image

- usually in upper 2/3 of esophagus (middle 1/3 = more likely)
- begins as in-situ lesion in the form of squamous dysplasia
- growth pattern; exophytic, excavated (ulcerative), infiltrative

describe the presentation of the condition seen in the image

- presentation:
- progressive dysphagia (to solids then to liquids)
- odynophagia
- cachexia
- fatigue (d/t melena → iron deficiency anemia)
- hematemesis
- hoarse voice and cough

describe investigations for the condition seen in the image

- investigations:
- GI endoscopy w/ biopsy: malignant squamous cells invading into the submucosa & muscularis propria
- barium swalllow: shows obstruction of lumen

describe complications of the condition seen in the image

- complications:
- can obstruct
- bleed (melena) → IDA
- perforate → mediastinitis
- form a TEF (food can get into lungs → aspiration pneumonia → lung abscess)
- can spread to cervical, mediastinal, paratracheal, tracheobronchial, gastric and celiac nodes depending on site of tumor
- direct metastasis to adjacent mediastinal structures including trachea and heart

describe the image

lymphoid aggregates with germinal centers and abundant subepithelial plasma cells within the superficial lamina propria are characteristic of H. pylori gastritis
describe the image

spiral-shaped H. pylori bacilli are highlighted with Warthin-Starry silver stain. Organisms are abundant within surface mucus
the condition seen in the image is caused by chronic infection with ___ at the ____ region of lesser curvature

the condition seen in the image is caused by chronic infection with H. pylori at the antro-pyloric region of lesser curvature

describe the histology of the condition seen in the image

- histology:
- reactive lymphoid aggregates
- chronic inflammatory infiltrate (lymphocytes, plasma cells) in lamina propria
- H. pylori is G-ve and not invasive
- therefore always seen on luminal surface
- addition of neutrophils = chronic ACTIVE gastritis

describe the pathogenesis of the condition seen in the image

- produces urease (urea → ammonia to neutralize acid) and phospholipase (destroys phospholipid bilayer in mucosa of stomach) → diffuse effacement of the mucosa by lymphocytes → chronic gastritis/peptic ulcers
- cytotoxin-associated gene A → increases risk for peptic ulcer disease and adenocarcinoma
- flagella → motility in mucoid environment

describe investigations of the condition seen in the image

- upper GI endoscopy + biopsy with Steiner Silver Stain
- black = organism
- microscopy:
- reactive lymphoid aggregates found just below epithelial lining (**hallmark of H. pylori**)
- inflammatory infiltrate in lamina propria
- PMNs in surface epithelium and glandular lumen
- intestinal metaplasia and glandular atrophy +/- dysplasia










































































































































































































































































